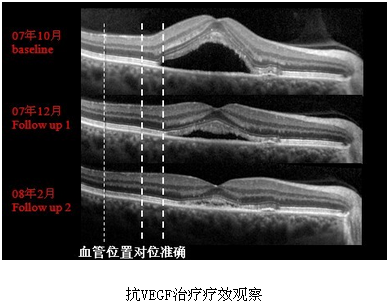
blob.png
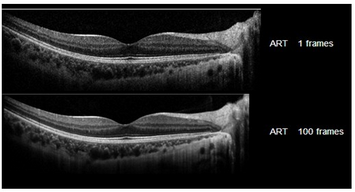
blob.png

尊敬的用户:根据《医疗器械监督管理条例》企业经营医疗器械提供相关经营资质,谢谢配合!
注册证号:国食药监械(进)字2014第3244501号
找维修
找配置
找授权
找证件
找寰熙
一、*清晰的频域OCT
海德堡OCT能够捕捉到不可思议的成像细节,能够辨认光感受器层组成成分,甚至更细微的细节,能够发现细微病变,解释疾病原因;减少漏诊,从而推动眼底病学发展。


二、唯一具有Eye-Tracking实时主动动眼追踪技术的OCT——“所见即所得”Eye-Tracking动眼追踪技术可以消除扫描伪迹,避免检查出现漏诊和误诊,并具有*好的重复性

Eye-Tracking动眼追踪技术衍生出TruTrackTM技术,实现随诊时精确同一位置,为精确量化评价疾病进展和治疗效果变化提供了可能——PDT和抗VEGF治疗疗效评估金标准
三、扫描速度*快的OCT—“海量数据”
应用全新的傅里叶解析技术,扫描速度高达40000 A-Scan/秒。

能在短时间获取大量数据,并对患者视网膜结构进行3D重建,全方位观察病变区域,防止漏诊

四、*新推出SPT联机软件,实现海德堡OCT、HRA两大系统交互、数据共享——“双剑合璧”
唯一可与海德堡造影联合升级成为造影与OCT同步显示,从而实现多达6种成像模式的多功能平台



SPT可实现造影平面影像学和OCT断面影像学的联合对位观察,对眼底疾病的诊断有非常重要的临床价值和意义
检查方便快速,多种手段综合评价疾病,全面多角度观察疾病,对疾病发病机理认识新突破,从而将眼底影像诊断水平推到了一个绝无仅有的高度
医生可在各个浏览终端根据cSLO图像自定义设置OCT扫描模式,按需进行OCT扫描
五、唯一具有ART(Automatic Real Time)技术的OCT
基于Eye-Tracking技术保障下的ART(Automatic Real Time)降噪技术,有效降低图像噪点,大大提高图像分辨率 :
ART启动利于定位眼底,针对性的检查病变区域

六、 唯一采用870nm光源扫描的OCT—适应症更广
白内障成像

白内障患者术前眼底彩照,晶体核Ⅳ级

在综合性术前检查的基础上为患者提供手术咨询
个人支付高端眼内人工晶体需要高端诊断工具以保证临床预后满意
提高白内障手术安全性和患者满意度
Spectralis-OCT提供完善的术前影像学检查资料,有效规避医疗风险
七、唯一具有个性化扫描方式的OCT
可以自定义扫描方式

可以实现任意区域扫描

医生可以根据病情进行个性化扫描,节约检查时间,提高临床效率
八、海德堡HEYEX多功能诊断平台,数据整合,资源共享

通过海德堡HEYEX多功能影像诊断平台,可将海德堡眼底诊断设备乃至眼科各类影像检查结果进行整合,完整记录患者检查资料,真正实现资源共享